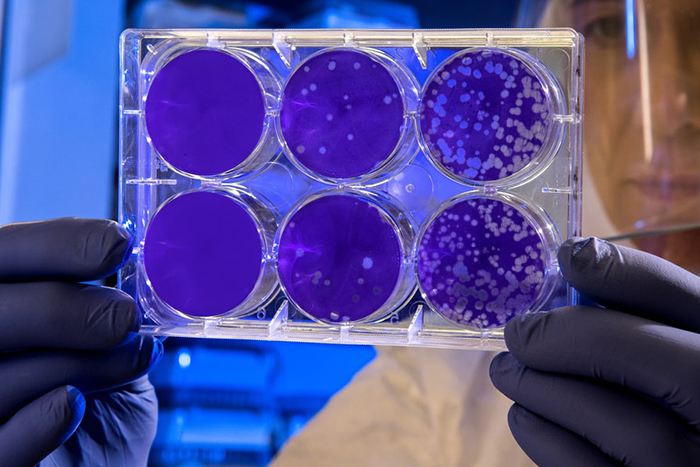

Правительство выделило 23 миллиарда рублей на борьбу с коронавирусом в России
Правительство России выделило около 23 миллиардов рублей на борьбу с коронавирусом в стране. Об этом сообщил премьер-министр Михаил Мишустин, передает «РИА Новости».
Деньги пойдут на поддержку медицинской и фармацевтической промышленности. Из этой суммы 7,5 миллиарда рублей пойдут на закупку аппаратов искусственной вентиляции легких, необходимых для больных с тяжелым течением инфекции.
Еще пять миллиардов направят на закупку теплотелевизионных регистаторов, бесконтактных термометров и установок обеззараживания воздуха. Фонду развития промышленности передадут 10 миллиардов рублей на производство и закупку оборудования и продукции для диагностики, выявления, профилактики и лечения эпидемических заболеваний.
Актуальные новости о распространении COVID-19 в городе читайте в рубрике «Бумаги» «Коронавирус в Петербурге».